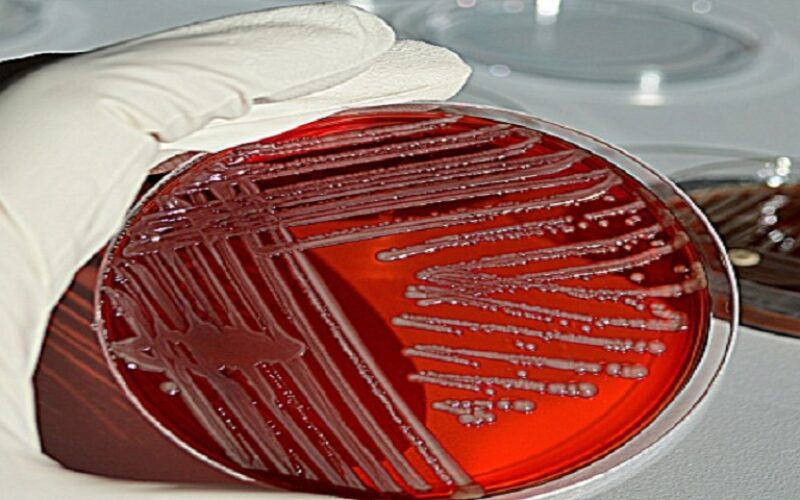

TEHNOLOGIJA
Siemens Healthcare prodaje mikrobiološko poslovanje Beckman Coulteru
Siemens Healthcare prodaje svoje mikrobiološko poslovanje Beckman Coulter Inc koja je u punom vlasništvu korporacije Danaher Corporation.




